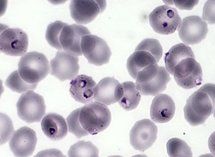
Le paludisme (Plasmodium falciparum, Protozoaires) : hématies polyparasitées par Plasmodium falciparum. Microscopie optique,

Tchad/Paludisme : Des soins et moustiquaires imprégnées d’insecticides gratuit dès 2011
Idriss Déby : Les dispositions prises par le Gouvernement ne peuvent atteindre leur objectif si elles ne sont soutenues par l’abnégation du personnel de la santé et la collaboration de la population bénéficiaire. C’est pourquoi j’en appelle au patriotisme et à la déontologie des médecins, des infirm
N'DJAMENA ( Tchad) - Le Président tchadien Idriss Déby a adressé un message au peuple tchadien a la veille de la journée mondiale de la lutte contre le paludisme.
"Parmi vous qui m’écoutez, mes chers compatriotes, il y a peut-être des milliers d’enfants, de femmes et d’hommes qui ont mal à la tête, qui ont de fortes fièvres ou des courbatures, bref des gens qui souffrent du paludisme. Si vous ne le sentez pas aujourd’hui, vous en avez certainement souffert auparavant. Le paludisme sévit dans toutes nos régions. Il rend faible, invalide parfois. Il est la cause de beaucoup de journées de travail perdues et, surtout, il tue plus de que toute autre maladie chez nous, même plus que le SIDA" a affirmé Idriss Déby dans son message.
Six cent millions de francs cfa ont été inscrit dans le budget de 2010 pour la prise en charge gratuite de tous les cas graves de paludisme tandis que le dépistage et le traitement d’un cas de paludisme grave coûtent environ 9.000 fcfa par patient.
"Dans une deuxième phase, et sans attendre la fin de l’année en cours, le Gouvernement saisira l’occasion d’un réajustement des crédits pour rendre également gratuite la prise en charge des diagnostics et des soins du paludisme simple pour les mères et les enfants sur l’ensemble du territoire national. Le dépistage et le traitement du paludisme simple coûtent entre 700 Fcfa et 1000 Fcfa par patient" annonce le Président.
"Dès l’année 2011, le Gouvernement ajoutera à ces services la distribution gratuite de moustiquaires imprégnées d’insecticides de longue durée" a-t-il rajouté.
Par la même occasion, il a remercié le Fonds Mondial pour la lutte contre le paludisme, l’OMS, l’Unicef, la Banque Islamique, la Banque Mondiale, la Croix Rouge et tous "les pays amis" qui apportent régulièrement leur soutien au Tchad dans la lutte contre le paludisme.
Le Président tchadien a conclu par un conseil aux tchadiens, le respect de l'hygiène pour faire face a la maladie du paludisme.


